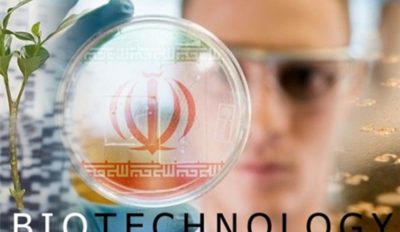

شركة أيرانية تلتف على الحظر وتصبح مصدّرة لأجهزة البايو
نجحت شركة معرفية ايرانية في الالتفاف على الحظر المفروض على معدات وتجهيزات البايوتكنولوجيا بل تحولت الى مصدّر لهذه التقنية والمعدات ايضا.
واستطاعت الشركة الايرانية المختصّة بانتاج تقنيات البايو والتي تضمّ خريجين من جامعات طهران وشريف وأميركبير، الالتفاف على الحظر بل وتصنيع مفاعلات البايو (فرمانتر) وتصديرها الى المانيا التي تعد قطبا عالميا في هذا القطاع التكنولوجي.
ويوفر جهاز الفرمانتر ظروفًا بيئية وفق معايير يتم التحكم فيها لنمو الجراثيم أو إنتاج مستقبلات محددة في بيئات سائلة أو صلبة في ظل ظروف معقمة.
وفي هذا السياق عدّ مدير الشركة اميرعباس اختراعي قطاع صناعة الدواء بالاستراتيجي والذي يرتبط بحياة البشر، لافتا الى ان البلدان الاجنبية تستغل الحظر وتبيع الادوية التي يحتاجها المرضى بأسعار مضاعفة لذلك ينبغي احراز التقدم والحد من تأثيرات الحظر.
ويشار الى ان اختراعي يحمل بكالوريوس في هندسة الميكانيك من جامعة شريف التكنولوجية وهو من مواليد 1972 وقام مع شقيقه خريج قسم هندسة الكيمياء من جامعة طهران بتأسيس شركة معرفية في مجال وضع تصاميم وتصنيع خطوط انتاجية للادوية والمعدات المرتبطة مع تقديم خدمات التركيب والصيانة والاصلاح.